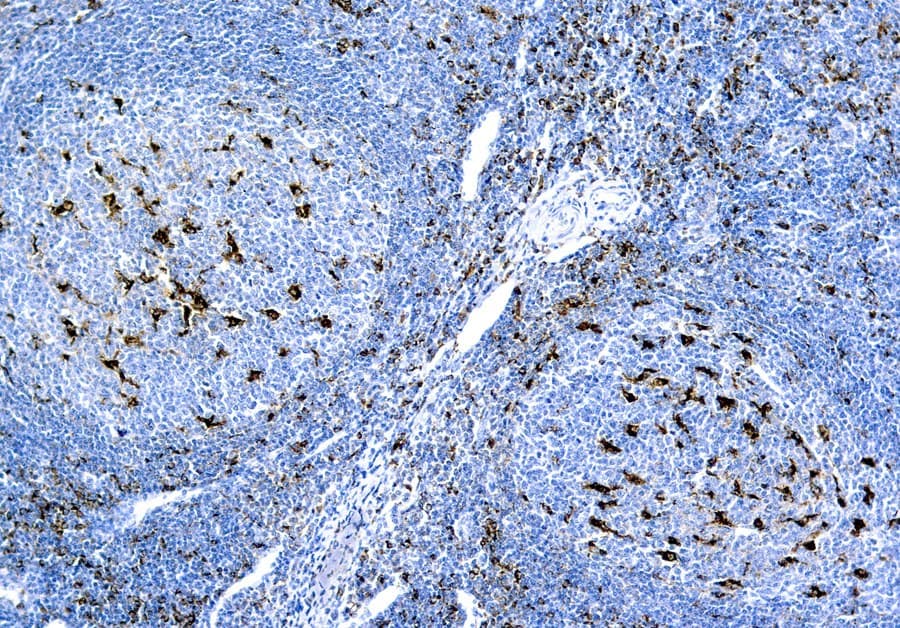

Anti-CD68 CE/IVD para IHC - Hematopatología
El clúster de diferenciación 68 (CD68) es un antígeno transmembrana fuertemente glicosilado que se detecta en lisosomas, macrófagos tisulares, células de Langerhans, células dendríticas, monocitos, células de Kupffer, osteoclastos y granulocitos. El antígeno CD68 está implicado en las actividades fagocíticas de los macrófagos tisulares, tanto en el metabolismo lisosomal intracelular como en las interacciones extracelulares célula-célula y célula-patógeno. El CD68 se une a lectinas y selectinas específicas de tejidos y órganos, lo que permite la localización de subconjuntos de macrófagos en lugares concretos. La rápida recirculación de CD68 desde los endosomas y lisosomas hasta la membrana plasmática ayuda a los macrófagos a desplazarse sobre sustratos portadores de selectinas y otras células. CD68 se expresa en gran medida en los monocitos sanguíneos y los macrófagos tisulares, así como en muchas líneas celulares tumorales, lo que favorece la unión a selectinas en el endotelio vascular y facilita la diseminación a lugares secundarios.
El Anti-CD68 puede ser útil para identificar tumores mielomonocíticos e histiocíticos, y para diferenciar entre histiocitoma fibroso maligno y otros sarcomas pleomórficos. Sin embargo, también pueden teñirse otras células ricas en lisosomas, ya que el Anti-CD68 detecta un epítopo resistente a la formalina que puede estar asociado a gránulos lisosomales.

Sección de amígdalas
Sección de amígdalas
Resultados de su búsqueda : 3 Producto encontrado
Refine su búsqueda :
RUO
CE/IVD
NEW
- human 3
- mouse 3
- Primary antibody
- IHC 3
- IHC068 3
Referencia
Descripción
Cond.
Precio Sin IVA
‹
›
